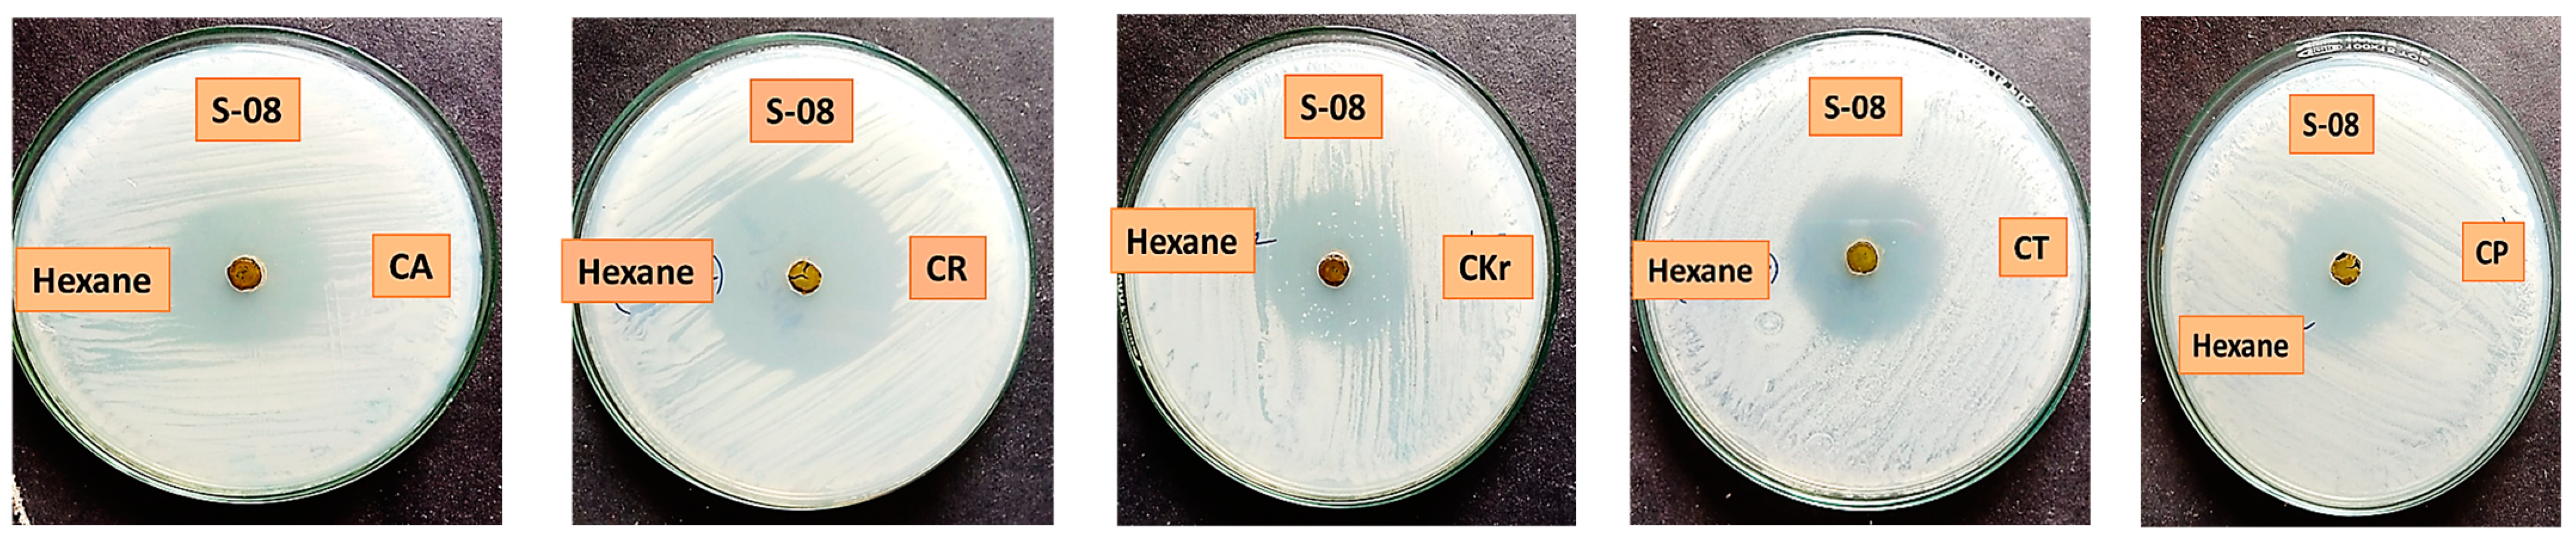

Anticandidal Properties of Launaea sarmentosa among the Salt Marsh Plants Collected from Palk Bay and the Gulf of Mannar Coast, Southeastern India
Abstract
1. Introduction
2. Results and Discussion
2.1. Phytochemical Screening
2.2. Anticandidal Assay
2.3. FT-IR Spectroscopy
2.4. GC-MS Analysis
3. Materials and Methods
3.1. Collection and Identification of Samples
3.2. Processing and Preparation of Samples
3.3. Chemical, Strains, and Media
3.4. Phytochemical Analysis
3.4.1. Alkaloid Detection (Wagner’s Test)
3.4.2. Flavonoid Identification (Alkaline Reagent Test)
3.4.3. Cardiac Glycoside Assay (Keller–Killiani Test)
3.4.4. Phenolic Compound Detection (Ferric Chloride Test)
3.4.5. Saponin Analysis (Froth Test)
3.4.6. Steroid (Salkowski’s Test)
3.4.7. Tannin Detection (Ferric Chloride Test)
3.4.8. Terpenoid Assay (Salkowski Test)
3.4.9. Coumarin Detection
3.4.10. Quinone
3.5. Anticandidal Screening
3.6. FTIR
3.7. GC-MS
4. Conclusions
Supplementary Materials
Author Contributions
Funding
Institutional Review Board Statement
Informed Consent Statement
Data Availability Statement
Acknowledgments
Conflicts of Interest
References
- Pappas, P.G.; Lionakis, M.S.; Arendrup, M.C.; Ostrosky-Zeichner, L.; Kullberg, B.J. Invasive candidiasis. Nat. Rev. Dis. Primers 2018, 4, 18026. [Google Scholar] [CrossRef] [PubMed]
- Hani, U.; Shivakumar, H.G.; Vaghela, R.; Osmani, A.M.; Shrivastava, A. Candidiasis: A fungal infection-current challenges and progress in prevention and treatment. Infect. Disord.-Drug Targets (Former. Curr. Drug Targets-Infect. Disord.) 2015, 15, 42–52. [Google Scholar] [CrossRef] [PubMed]
- Pappas, P.G.; Kauffman, C.A.; Andes, D.; Benjamin, D.K., Jr.; Calandra, T.F.; Edwards, J.E., Jr.; Filler, S.G.; Fisher, J.F.; Kullberg, B.-J.; Zeichner, L.O. Clinical practice guidelines for the management of candidiasis: 2009 update by the Infectious Diseases Society of America. Clin. Infect. Dis. Off. Publ. Infect. Dis. Soc. Am. 2009, 48, 503. [Google Scholar] [CrossRef] [PubMed]
- Arumugam, G.; Rajendran, R.; Khaleelullah, N.S.; Ramanathan, S. Anticandidal and anti-virulence efficiency of selected seaweeds against azole resistance Candida albicans. Biocatal. Agric. Biotechnol. 2019, 20, 101195. [Google Scholar] [CrossRef]
- Munn, C.B. Marine Microbiology: Ecology & Applications; CRC Press: Boca Raton, FL, USA, 2019. [Google Scholar]
- Bhowmik, S. Ecological and economic importance of wetlands and their vulnerability: A review. In Research Anthology on Ecosystem Conservation and Preserving Biodiversity; CRC Press: Boca Raton, FL, USA, 2022; pp. 11–27. [Google Scholar]
- Zedler, J.B.; Kercher, S. Wetland resources: Status, trends, ecosystem services and restorability. Annu. Rev. Environ. Resour. 2005, 30, 39–74. [Google Scholar] [CrossRef]
- Anjum, N.A.; Ahmad, I.; Valega, M.; Mohmood, I.; Gill, S.S.; Tuteja, N.; Duarte, A.C.; Pereira, E. Salt marsh halophyte services to metal–metalloid remediation: Assessment of the processes and underlying mechanisms. Crit. Rev. Environ. Sci. Technol. 2014, 44, 2038–2106. [Google Scholar] [CrossRef]
- Bora, L. Anticandidal activity of medicinal plants and Pseudomonas aeruginosa strains of clinical specimens. J. Microbiol. Immunol. Infect. 2016, 49, 276–280. [Google Scholar] [CrossRef] [PubMed][Green Version]
- Potente, G.; Bonvicini, F.; Gentilomi, G.A.; Antognoni, F. Anti-Candida activity of essential oils from Lamiaceae plants from the Mediterranean area and the Middle East. Antibiotics 2020, 9, 395. [Google Scholar] [CrossRef]
- Kader, M.A.; Hasan, M.R.; Parvez, G.M.; Parvin, S. Phytochemical Screening and Antimicrobial Evaluation of Various Fractionates of Ethanolic Extract of Launaea sarmentosa (Willd.), in the Search of Possible Candidates to Multidrug Resistant Microbes. J. Pharm. Sci. Res. 2022, 14, 811–817. [Google Scholar]
- Akbar, W.A.S.; Arokiarajan, M.S.; Christopher, J.J.; Ahmed, N.Z.; Meena, R. Evaluation of bioactive compounds as antimicrobial and antidiabetic agent from the crude extract of Heliotropium curassavicum L. Biocatal. Agric. Biotechnol. 2023, 50, 102745. [Google Scholar]
- Mohamed, N.A.F.; Al-Touby, S.S.; Hossain, M.A. Evaluation of cytotoxic and antioxidant activities of different polarities extracts of Suaeda maritima. Biocatal. Agric. Biotechnol. 2022, 42, 102370. [Google Scholar] [CrossRef]
- El-Aasr, M.; Kabbash, A.; El-Seoud, K.A.A.; Al-Madboly, L.A.; Ikeda, T. Antimicrobial and Immunomodulatory Activities of Flavonol Glycosides Isolated from Atriplex halimus L. Herb. J. Pharm. Sci. Res. 2016, 8, 1159. [Google Scholar]
- Ghori, M.K.; Ghaffari, M.A.; Hussain, S.N.; Manzoor, M.; Aziz, M.; Sarwer, W. Ethnopharmacological, phytochemical and pharmacognostic potential of genus Heliotropium L. Turk. J. Pharm. Sci. 2016, 13, 143–168. [Google Scholar] [CrossRef]
- Prapasanobol, V. Biological activities and preliminary phytochemical examination of the roots of the twelve zodiac signs. Sci. Technol. Nakhon Sawan Rajabhat Univ. J. 2018, 10, 89–100. [Google Scholar]
- Makauki, E.; Mtavangu, S.G.; Basu, O.D.; Rwiza, M.; Machunda, R. Facile biosynthesis of Ag–ZnO nanocomposites using Launaea cornuta leaf extract and their antimicrobial activity. Discov. Nano 2023, 18, 142. [Google Scholar] [CrossRef]
- Hanh, L.H.; Dung, P.D.; Huy, L.D.; Duong, N.T.T.; Wacharasindhu, S.; Phung, N.K.P.; Chi, H.B.L. Chemical constituents of Launaea sarmentosa roots. Vietnam. J. Chem. 2020, 58, 637–642. [Google Scholar] [CrossRef]
- Melo, C.M.; Morais, T.C.; Tomé, A.R.; Brito, G.A.C.; Chaves, M.H.; Rao, V.S.; Santos, F.A. Anti-inflammatory effect of α,β-amyrin, a triterpene from Protium heptaphyllum, on cerulein-induced acute pancreatitis in mice. Inflamm. Res. 2011, 60, 673–681. [Google Scholar] [CrossRef] [PubMed]
- Ahsan, T.; Chen, J.; Zhao, X.; Irfan, M.; Wu, Y. Extraction and identification of bioactive compounds (eicosane and dibutyl phthalate) produced by Streptomyces strain KX852460 for the biological control of Rhizoctonia solani AG-3 strain KX852461 to control target spot disease in tobacco leaf. AMB Express 2017, 7, 54. [Google Scholar] [CrossRef]
- Beema Shafreen, R.M.; Seema, S.; Alagu Lakshmi, S.; Srivathsan, A.; Tamilmuhilan, K.; Shrestha, A.; Muthupandian, S. In vitro and in vivo antibiofilm potential of eicosane against Candida albicans. Appl. Biochem. Biotechnol. 2022, 194, 4800–4816. [Google Scholar] [CrossRef]
- Balachandran, A.; Siyumbwa, S.N.; Froemming, G.R.; Beata, M.M.; Małgorzata, J.; Lavilla, C.A., Jr.; Billacura, M.P.; Okechukwu, P.N. In Vitro Antioxidant and Fibroblast Migration Activities of Fractions Eluded from Dichloromethane Leaf Extract of Marantodes pumilum. Life 2023, 13, 1409. [Google Scholar] [CrossRef]
- Gopi, M.; Kumar, M.P.; Jeevamani, J.J.J.; Raja, S.; Muruganandam, R.; Samuel, V.D.; Simon, N.T.; Viswanathan, C.; Abhilash, K.; Krishnan, P.; et al. Distribution and biodiversity of tropical saltmarshes: Tamil Nadu and Puducherry, Southeast coast of India. Estuar. Coast. Shelf Sci. 2019, 229, 106393. [Google Scholar] [CrossRef]
- Viswanathan, C.; Purvaja, R.; Jeevamani, J.J.J.; Samuel, V.D.; Sankar, R.; Abhilash, K.R.; Geevargheese, G.A.; Muruganandam, R.; Gopi, M.; Raja, S.; et al. Salt marsh vegetation in India: Species composition, distribution, zonation pattern and conservation implications. Estuar. Coast. Shelf Sci. 2020, 242, 106792. [Google Scholar] [CrossRef]
- Ramesh, R.; Nammalwar, P.; Gowri, V.S. Database on Coastal Information of Tamilnadu; Report submitted to Environmental Information System (ENVIS); Institute for Ocean Management, Anna University: Chennai, India; Department of Environment, Government of Tamilnadu: Chennai, India, 2008; 133p. [Google Scholar]
- Banerjee, L.K.; Sastry, A.R.K.; Nayar, M.P. Mangroves in India: Identification Manual; Botanical Survey of India: Howrah, India, 1989. [Google Scholar]
- Selvam, V.; Eganathan, P.; Karunagaran, V.M.; Ravishankar, T.; Ramasubramanian, R. Mangrove Plants of Tamil Nadu; MS Swaminathan Research Foundation: Chennai, India, 2004; 56p. [Google Scholar]
- Salih, Y.; Harisha, C.R.; Shukla, V.J.; Acharya, R. Pharmacognostical evaluation of Launaea sarmentosa (Willd.) schultz-bip. ex Kuntze root. Ayu 2013, 34, 90. [Google Scholar] [CrossRef] [PubMed]
- Priyanka, K.R.; Rajaram, R. Preliminary screening on anticandidal properties of marine macroalgae collected from Palk Bay and Gulf of Mannar, southeast coast of India. Biomass Convers. Biorefinery 2022, 1–10. [Google Scholar] [CrossRef]
- Ramasar, R.; Naidoo, Y.; Dewir, Y.H.; El-Banna, A.N. Seasonal change in phytochemical composition and biological activities of Carissa macrocarpa (Eckl.) A. DC. leaf extract. Horticulturae 2022, 8, 780. [Google Scholar] [CrossRef]
- Surendra, T.V.; Roopan, S.M.; Arasu, M.V.; Al-Dhabi, N.A.; Sridharan, M. Phenolic compounds in drumstick peel for the evaluation of antibacterial, hemolytic and photocatalytic activities. J. Photochem. Photobiol. B Biol. 2016, 161, 463–471. [Google Scholar] [CrossRef] [PubMed]
- María, R.; Shirley, M.; Xavier, C.; Jaime, S.; David, V.; Rosa, S.; Jodie, D. Preliminary phytochemical screening, total phenolic content and antibacterial activity of thirteen native species from Guayas province Ecuador. J. King Saud Univ.-Sci. 2018, 30, 500–505. [Google Scholar] [CrossRef]
- Kancherla, N.; Dhakshinamoothi, A.; Chitra, K.; Komaram, R.B. Preliminary analysis of phytoconstituents and evaluation of anthelminthic property of Cayratia auriculata (in vitro). Maedica 2019, 14, 350. [Google Scholar]
- Das, B.K.; Al-Amin, M.M.; Russel, S.M.; Kabir, S.; Bhattacherjee, R.; Hannan, J.M.A. Phytochemical screening and evaluation of analgesic activity of Oroxylum indicum. Indian J. Pharm. Sci. 2014, 76, 571. [Google Scholar]
- Sofowora, A. Research on medicinal plants and traditional medicine in Africa. J. Altern. Complement. Med. 1996, 2, 365–372. [Google Scholar] [CrossRef]
- Harborne, A.J. Phytochemical Methods a Guide to Modern Techniques of Plant Analysis; Springer Science and Business Media: Berlin/Heidelberg, Germany, 1998. [Google Scholar]
- Aravinth, A.; Mohan, P.K.; Perumal, P.; Dhanasundaram, S.; Kamaraj, C.; Rajaram, R. Phyto-fabrication of brown seaweed Dictyota ciliolata extract towards silver nanoparticles synthesis and evaluation of mosquito-larvicidal potential of the synthesized AgNPs. J. Appl. Phycol. 2024, 36, 2311–2323. [Google Scholar] [CrossRef]
- Pourakbar, L.; Moghaddam, S.S.; Enshasy, H.A.E.; Sayyed, R.Z. Antifungal activity of the extract of a macroalgae, Gracilariopsis persica, against four plant pathogenic fungi. Plants 2021, 10, 1781. [Google Scholar] [CrossRef] [PubMed]

| Tests | Heliotropium curassavicum | Sesuvium portulacastrum | Suaeda maritima | Launaea sarmentosa | |||||
|---|---|---|---|---|---|---|---|---|---|
| Acetone | Ethyl Acetate | Acetone | Ethyl Acetate | Acetone | Ethyl Acetate | Acetone | Ethyl Acetate | Hexane | |
| Alkaloids | ++ | ++ | ++ | ++ | ++ | ++ | ++ | ++ | ++ |
| Flavonoids | - | ++ | - | ++ | ++ | ++ | - | ++ | - |
| Glycosides | - | ++ | ++ | - | ++ | - | ++ | ++ | - |
| Phenolic groups | - | ++ | - | - | - | ++ | - | ++ | ++ |
| Saponins | - | - | - | - | - | - | - | - | ++ |
| Steroids | ++ | ++ | - | ++ | ++ | ++ | ++ | ++ | ++ |
| Tannins | ++ | ++ | ++ | ++ | ++ | ++ | ++ | ++ | ++ |
| Terpenoids | ++ | ++ | ++ | ++ | ++ | ++ | ++ | ++ | ++ |
| Coumarins | ++ | - | ++ | ++ | ++ | ++ | ++ | ++ | ++ |
| Quinones | ++ | - | ++ | - | ++ | - | ++ | ++ | - |
| Sample ID | SM1 | SM2 | SM3 | SM4 | SM5 | SM6 | SM7 | SM8 | SM9 | SM10 | Control | |
|---|---|---|---|---|---|---|---|---|---|---|---|---|
| Acetone | CA | 10 ± 0.3 | 10 ± 0.5 | 10 ± 0.5 | 9 ± 0.4 | 10 ± 0.36 | 10 ± 0.23 | - | 9 ± 0.21 | 9 ± 0.55 | - | 21 ± 0.24 |
| CK | 11 ± 0.8 | 11 ± 0.7 | 12 ± 0.9 | 10 ± 0.5 | 9 ± 0.41 | - | 9 ± 0.16 | 10 ± 0.9 | 9 ± 0.17 | 10 ± 0.35 | 18 ± 0.4 | |
| CKr | 10 ± 0.5 | 9 ± 0.3 | 10 ± 0.3 | 9 ± 0.8 | 10 ± 0.6 | - | - | 9 ± 0.6 | 9 ± 0.8 | - | 18 ± 0.6 | |
| CT | 10 ± 0.7 | 9 ± 0.5 | 10 ± 0.4 | 10 ± 0.6 | 11 ± 0.62 | - | - | 10 ± 0.9 | 10 ± 0.9 | - | 20 ± 0.6 | |
| CP | 10 ± 0.4 | 10 ± 0.6 | 11 ± 0.7 | 9 ± 0.15 | 10 ± 0.39 | - | - | 10 ± 0.57 | 9 ± 0.7 | - | 18 ± 0.2 | |
| Ethyl acetate | CA | 11 ± 0.76 | 11 ± 0.36 | 18 ± 0.45 | 11 ± 0.78 | 13 ± 0.59 | 9 ± 0.37 | 10 ± 0.32 | 13 ± 0.87 | 9 ± 0.6 | 8 ± 0.3 | 16 ± 0.6 |
| CK | 11 ± 0.6 | 12 ± 0.74 | 19 ± 0.59 | 12 ± 0.36 | 16 ± 0.7 | 9 ± 0.4 | 10 ± 0.71 | 13 ± 0.35 | 9 ± 0.7 | 9 ± 0.4 | 18 ± 0.3 | |
| CKr | 10 ± 0.36 | 10 ± 0.22 | 20 ± 0.86 | 12 ± 0.49 | 13 ± 0.77 | - | 9 ± 0.33 | 13 ± 0.25 | - | - | 21 ± 0.9 | |
| CT | 10 ± 0.21 | 11 ± 0.6 | 19 ± 0.9 | 12 ± 0.67 | 13 ± 0.41 | 10 ± 0.6 | 10 ± 0.9 | 15 ± 0.61 | 9 ± 0.9 | 9 ± 0.7 | 19 ± 0.3 | |
| CP | 12 ± 0.21 | 13 ± 0.46 | 18 ± 0.76 | 12 ± 0.58 | 15 ± 0.36 | - | 9 ± 0.36 | 13 ± 0.28 | 10 ± 0.57 | 10 ± 0.33 | 20 ± 0.41 | |
| Methanol | CA | - | - | 9 ± 0.6 | - | - | 10 ± 0.9 | - | - | - | 10 ± 0.51 | 21 ± 0.76 |
| CK | - | 9 ± 0.23 | - | 10 ± 0.12 | - | 10 ± 0.5 | - | 10 ± 0.91 | - | 10 ± 0.84 | 18 ± 0.6 | |
| CKr | 10 ± 0.8 | - | - | 9 ± 0.35 | 10 ± 0.26 | - | - | 8 ± 0.2 | - | - | 20 ± 0.16 | |
| CT | 9 ± 0.7 | 9 ± 0.41 | 9 ± 0.36 | 9 ± 0.9 | - | - | - | - | - | -- | 18 ± 0.12 | |
| CP | - | 9 ± 0.22 | 9 ± 0.5 | 9 ± 0.17 | - | - | - | - | - | 10 ± 0.24 | 21 ± 0.36 | |
| Hexane | CA | - | - | - | - | - | - | - | 30 ± 0.23 | - | - | 21 ± 0.16 |
| CK | - | 10 ± 0.33 | - | - | 8 ± 0.75 | - | 30 ± 0.95 | 38 ± 0.71 | - | 26 ± 0.65 | 22 ± 0.26 | |
| CKr | - | - | - | - | - | 9 ± 0.36 | - | 29 ± 0.46 | - | - | 18 ± 0.71 | |
| CT | - | 9 ± 0.14 | 9 ± 0.5 | - | - | 10 ± 0.9 | - | - | 31 ± 0.67 | - | 20 ± 0.25 | |
| CP | - | 9 ± 0.7 | 9 ± 0.62 | - | - | - | - | - | 27 ± 0.94 | - | 23 ± 0.8 | |
| Sample ID | SM1 | SM2 | SM3 | SM4 | SM5 | SM6 | SM7 | SM8 | SM9 | SM10 | Control | |
|---|---|---|---|---|---|---|---|---|---|---|---|---|
| Acetone | CA | 7 ± 0.6 | 8 ± 0.8 | 8 ± 0.4 | 9 ± 0.9 | 8 ± 0.45 | 8 ± 0.61 | - | 8 ± 0.15 | 6 ± 0.63 | - | 18 ± 0.21 |
| CK | 9 ± 0.31 | 9 ± 0.81 | 9 ± 0.22 | 6 ± 0.17 | 7 ± 0.36 | - | 6 ± 0.32 | 6 ± 0.21 | 7 ± 0.16 | 8 ± 0.37 | 22 ± 0.4 | |
| CKr | 8 ± 0.32 | 8 ± 0.45 | 8 ± 0.23 | 10 ± 0.21 | 9 ± 0.55 | - | - | 9 ± 0.19 | 6 ± 0.43 | - | 21 ± 0.14 | |
| CT | 10 ± 0.87 | 8 ± 0.36 | 8 ± 0.23 | 9 ± 0.3 | 9 ± 0.19 | 8 ± 0.32 | - | 7 ± 0.6 | 7 ± 0.4 | - | 18 ± 0.4 | |
| CP | 9 ± 0.22 | 7 ± 0.96 | 6 ± 0.4 | 10 ± 0.31 | 8 ± 0.9 | - | - | 8 ± 0.7 | 8 ± 0.13 | - | 20 ± 0.24 | |
| Ethyl acetate | CA | 9 ± 0.18 | 9 ± 0.3 | 10 ± 0.8 | 9 ± 0.63 | 10 ± 0.16 | 6 ± 0.25 | - | 9 ± 0.28 | 7 ± 0.8 | 8 ± 0.9 | 19 ± 0.14 |
| CK | 9 ± 0.31 | 10 ± 0.65 | 10 ± 0.87 | 10 ± 0.41 | 10 ± 0.30 | 7 ± 0.4 | - | 10 ± 0.6 | 8 ± 0.17 | 9 ± 0.22 | 20 ± 0.23 | |
| CKr | 8 ± 0.8 | - | - | 8 ± 0.37 | - | - | - | - | - | - | 18 ± 0.41 | |
| CT | 9 ± 0.21 | 7 ± 0.12 | 10 ± 0.38 | 10 ± 0.44 | 10 ± 0.9 | - | - | 10 ± 0.87 | 9 ± 0.31 | - | 22 ± 0.44 | |
| CP | 8 ± 0.33 | 7 ± 0.11 | 8 ± 0.41 | 10 ± 0.36 | 9 ± 0.25 | 8 ± 0.9 | 8 ± 0.17 | 11 ± 0.9 | - | - | 21 ± 0.24 | |
| Methanol | CA | - | - | 8 ± 0.8 | - | - | 8 ± 0.7 | - | - | - | 8 ± 0.2 | 16 ± 0.4 |
| CK | - | 8 ± 0.75 | - | 9 ± 0.25 | - | - | - | 8 ± 0.37 | - | 9 ± 0.9 | 18 ± 0.14 | |
| CKr | - | - | - | 8 ± 0.17 | 9 ± 0 | - | - | 7 ± 0.14 | - | - | 15 ± 0.34 | |
| CT | - | - | - | 8 ± 0.70 | - | - | - | - | - | - | 19 ± 0.4 | |
| CP | - | 7 ± 0.64 | - | - | - | - | - | - | - | 9 ± 0.33 | 20 ± 0.23 | |
| Hexane | CA | - | - | - | - | - | - | - | 24 ± 0.58 | - | - | 22 ± 0.42 |
| CK | - | - | - | - | 8 ± 0.21 | - | 22 ± 0.87 | 26 ± 0.78 | - | 20 ± 0.45 | 23 ± 0.17 | |
| CKr | - | - | - | - | - | - | - | 22 ± 0.98 | - | - | 18 ± 0.29 | |
| CT | - | - | 8 ± 0.8 | - | - | - | - | 20 ± 0.47 | - | - | 19 ± 0.4 | |
| CP | - | 8 ± 0.70 | - | - | - | - | - | - | 18 ± 0.37 | - | 20 ± 0.22 | |
| S. No | Absorption (cm−1) | Vibration Mode | Compound Class |
|---|---|---|---|
| 1 | 2916.81 | N–H stretching | amine salt |
| 2 | 2849.31 | C–H stretching | Alkane |
| 3 | 2361.41 | O=C=O stretching | carbon dioxide |
| 4 | 1735.62 | C=O stretching | Aldehyde |
| 5 | 1461.78 | C–H bending | Alkane |
| 6 | 1378.85 | O–H bending | Phenol |
| 7 | 1260.25 | C–O stretching | aromatic ester |
| 8 | 1094.4 | C–O stretching | secondary alcohol |
| 9 | 1027.87 | C–N stretching | Amine |
| 10 | 879.381 | C=C bending | Alkene |
| 11 | 802.242 | C–H bending | 1,4-disubstituted, 1,2,3,4-tetrasubstituted |
| 12 | 719.318 | C=C bending | Alkene |
| Peaks | RT (min) | Area % | Molecular Weight | Molecular Formula | Compound Names |
|---|---|---|---|---|---|
| 1 | 4.442 | 0.47 | 163.06 | C6H11Br | Cyclopropane, 2-bromo-1,1,3-trimethyl- |
| 2 | 6.542 | 0.33 | 254.5 | C18H38 | Pentadecane, 2,6,10-trimethyl- |
| 3 | 7.509 | 0.27 | 216.38 | C14H29F | Tetradecyl fluoride |
| 4 | 11.819 | 0.59 | 202.33 | C12H26O2 | 1-Methoxy-3-(2-hydroxyethyl)nonane |
| 5 | 14.463 | 0.3 | 138.3 | H6O3Si3 | Cyclotrisiloxane |
| 6 | 15.385 | 0.27 | 278.5 | C17H30Osi | Trimethyl[4-(1,1,3,3,-tetramethylbutyl)phenoxy]silane |
| 7 | 15.808 | 1.08 | 240.5 | C17H36 | Heptadecane |
| 8 | 16.319 | 0.5 | 226.44 | C16H34 | Hexadecane |
| 9 | 16.519 | 0.28 | 222.4 | C13H22Osi | Silane, trimethyl[5-methyl-2-(1-methylethyl)phenoxy]- |
| 10 | 16.819 | 1.18 | 282.5 | C20H42 | Eicosane |
| 11 | 17.152 | 0.39 | 222.46 | C6H18O3Si3 | Cyclotrisiloxane, hexamethyl- |
| 12 | 17.296 | 0.55 | 250.48 | C13H22OSi2 | 2,4,6-Cycloheptatrien-1-one, 3,5-bis-trimethylsilyl |
| 13 | 17.53 | 2.54 | 366.6 | C24H46O2 | (Z)-14-Tricosenyl formate |
| 14 | 17.863 | 19.03 | 336.6 | C24H48 | Cyclotetracosane |
| 15 | 18.096 | 1.07 | 264.46 | C13H20N2SSi | 1,2-Benzisothiazol-3-amine tbdms |
| 16 | 18.418 | 0.54 | 222.47 | C12H22Si2 | Silane, 1,4-phenylenebis[trimethyl |
| 17 | 18.741 | 5.32 | 282.5 | C19H38O | Oxirane, heptadecyl |
| 18 | 19.107 | 0.56 | 346.6 | C20H42O2S | Di-n-decylsulfone |
| 19 | 19.174 | 1.04 | 207.27 | C12H17NO2 | hexahydropyridine, 1-methyl-4-[4,5 -dihydroxyphenyl]- |
| 20 | 19.485 | 0.55 | 264.43 | C15H24O2Si | Trimethyl[4-(2-methyl-4-oxo-2-pentyl)phenoxy]silane |
| 21 | 20.374 | 6.4 | 268.5 | C18H36O | Octadecanal |
| 22 | 20.651 | 0.85 | 310.68 | C10H30O3Si4 | Tetrasiloxane, decamethyl- |
| 23 | 21.007 | 0.41 | 242.65 | C14H7ClO2 | 9-Fluorenone-4-carbonyl chloride |
| 24 | 21.285 | 0.61 | 250.38 | C16H26O2 | Hexanoic acid, 2,7-dimethyloct-7-en-5-yn-4-yl ester |
| 25 | 21.507 | 2.97 | 218.33 | C15H22O | 2(1H)Naphthalenone, 3,5,6,7,8,8a-hexahydro-4,8a-dimethyl-6-(1-methylethenyl)- |
| 26 | 21.862 | 12.66 | 426.7 | C30H50O | β-amyrin |
| 27 | 22.051 | 3.71 | 218.25 | C16H10O | Benzo[b]naphtho[2,3-d]furan |
| 28 | 22.429 | 24.16 | 426.7 | C30H50O | Lupeol |
| 29 | 22.618 | 1 | 310.68 | C10H30O3Si4 | Methyltris(trimethylsiloxy)silane |
| 30 | 22.873 | 10.35 | 468.8 | C32H52O2 | 12-Oleanen-3-yl acetate |
| Location | Sites | Latitude | Longitude |
|---|---|---|---|
| Rameswaram | Site 1 | 9°16′54.5″ N | 79°11′04.5″ E |
| Site 2 | 9°16′55.2″ N | 79°11′19.3″ E | |
| Site 3 | 9°16′52.2″ N | 79°11′21.4″ E | |
| Dhanushkodi | Site 4 | 9°12′07.2″ N | 79°22′38.9″ E |
| Rameswaram | Site 5 | 9°17′02.1″ N | 79°10′41.5″ E |
| Dhanushkodi | Site 6 | 9°10′04.6″ N | 79°25′46.0″ E |
| Site 7 | 9°09′58.7″ N | 79°25′53.2″ E | |
| Site 8 | 9°09′56.7″ N | 79°25′54.3″ E |
| Sample ID | Name of the Species | Site 1 | Site 2 | Site 3 | Site 4 | Site 5 | Site 6 | Site 7 | Site 8 |
|---|---|---|---|---|---|---|---|---|---|
| SM1 | Heliotropium curassavicum | + | |||||||
| SM2 | Sesuvium portulacastrum | + | |||||||
| SM3 | Suaeda maritima | + | |||||||
| SM4 | Ipomoea pes-caprae | + | |||||||
| SM5 | Atriplex halimus | + | |||||||
| SM6 | Salicornia brachiata | + | |||||||
| SM7 | Spinifex littoreus | + | |||||||
| SM8 | Launaea sarmentosa | + | |||||||
| SM9 | Fimbristylis spathacea | + | |||||||
| SM10 | Bulbostylis barbata | + |
Disclaimer/Publisher’s Note: The statements, opinions and data contained in all publications are solely those of the individual author(s) and contributor(s) and not of MDPI and/or the editor(s). MDPI and/or the editor(s) disclaim responsibility for any injury to people or property resulting from any ideas, methods, instructions or products referred to in the content. |
© 2024 by the authors. Licensee MDPI, Basel, Switzerland. This article is an open access article distributed under the terms and conditions of the Creative Commons Attribution (CC BY) license (https://creativecommons.org/licenses/by/4.0/).
Share and Cite
Das, S.; Priyanka, K.R.; Prabhu, K.; Vinayagam, R.; Rajaram, R.; Kang, S.G. Anticandidal Properties of Launaea sarmentosa among the Salt Marsh Plants Collected from Palk Bay and the Gulf of Mannar Coast, Southeastern India. Antibiotics 2024, 13, 748. https://doi.org/10.3390/antibiotics13080748
Das S, Priyanka KR, Prabhu K, Vinayagam R, Rajaram R, Kang SG. Anticandidal Properties of Launaea sarmentosa among the Salt Marsh Plants Collected from Palk Bay and the Gulf of Mannar Coast, Southeastern India. Antibiotics. 2024; 13(8):748. https://doi.org/10.3390/antibiotics13080748
Chicago/Turabian StyleDas, Smriti, Karuppannagounder Rajan Priyanka, Kolandhasamy Prabhu, Ramachandran Vinayagam, Rajendran Rajaram, and Sang Gu Kang. 2024. "Anticandidal Properties of Launaea sarmentosa among the Salt Marsh Plants Collected from Palk Bay and the Gulf of Mannar Coast, Southeastern India" Antibiotics 13, no. 8: 748. https://doi.org/10.3390/antibiotics13080748
APA StyleDas, S., Priyanka, K. R., Prabhu, K., Vinayagam, R., Rajaram, R., & Kang, S. G. (2024). Anticandidal Properties of Launaea sarmentosa among the Salt Marsh Plants Collected from Palk Bay and the Gulf of Mannar Coast, Southeastern India. Antibiotics, 13(8), 748. https://doi.org/10.3390/antibiotics13080748

